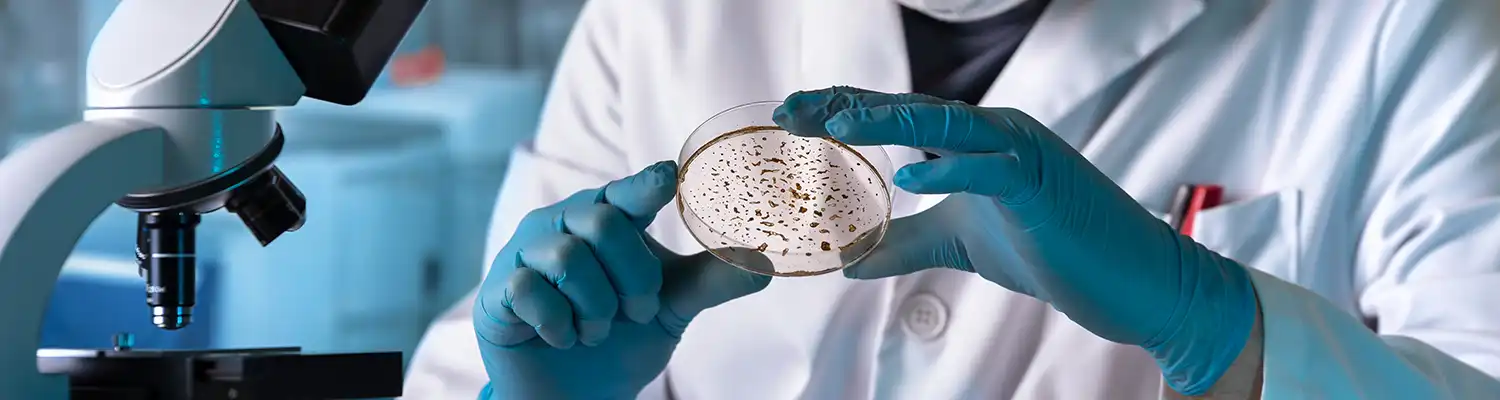
close up of hands holding a petri dish for examination

Biological Sciences, PhD PhD
The Department of Biological Sciences offers graduate programs in biology with areas of concentration in botany; microbiology; cellular and molecular biology; genetics; physiology and morphology of plants and animals; terrestrial and aquatic ecology; behavioral biology; conservation biology; and evolution.
Program Type
Doctoral
Program Format
On Campus
Application to all graduate programs are completed through the UWM Graduate School. Please see their website for detailed information about the application process and contact them with questions.
We also have provided information about applying to one of the Biological Sciences graduate programs and our admissions criteria:
Admission Requirements
Application Deadlines
Application deadlines vary by program, please review the application deadline chart for specific programs. Other important dates and deadlines can be found by using the One Stop calendars.
Admission
An applicant must meet Graduate School requirements plus the following program requirements to be considered for admission:
- Applicant must present at least 30 credits in one or more areas of biological sciences and must show substantial evidence of scholarly potential. A master’s degree is not prerequisite for admission to the PhD program.
- Other academic preparation: a year of general physics including at least one semester of laboratory; one year of general college chemistry with laboratory, plus at least one semester of organic chemistry with laboratory or biochemistry with laboratory; two courses in college mathematics chosen from among courses in calculus, biometry or statistics.
- Submission of a reasons statement, outlining your academic and scientific background, reason for pursuing graduate studies, specific research area, why you decided to apply to the program and the names of faculty members with whom you would like to study (you can browse our research page to find a list of faculty and their research interests). Prior to listing them in your application, please contact the faculty members of interest via email to see if they are accepting new students.
- Submission of a resume/CV.
- Optional submission of scores on the General Test of the Graduate Record Examination.
- Acceptance by a faculty member in the program who will act as major professor (sponsor): see Major Professor as Advisor.
- Three letters of recommendation from persons familiar with the applicant’s scholarship, research achievements and potential.
- International students must meet the minimum department requirements for English proficiency:
- Completion of a baccalaureate or higher degree within the last two years from an institution where English is the sole language of instruction with a minimum of two years attendance; or
- A minimum required TOEFL score of 79 overall with a minimum required score of 24 on the Speaking portion; or
- A minimum required IELTS score of 6.5 overall with a minimum required score of 7.0 on the Speaking portion; or
- A minimum required CAE score of C1 overall with a minimum required score of 185 on the Speaking portion; or
- A minimum required Duolingo score of 120 overall with a minimum required score of 125 on the Conversation and Production sections.
Applicants may be admitted with specific course deficiencies provided that the deficiencies amount to no more than two courses. The student is expected to satisfy deficiency requirements with a grade of C or better within three enrolled semesters. The deficiencies are monitored by the Graduate School and the individual graduate program unit. No course credits earned in making up deficiencies may be counted as program credits required for the degree. The student is expected to maintain a grade of B in all other coursework.
Reapplication
A student in the MS program, or who receives the master’s degree at UWM, must formally reapply for admission to the Graduate School before continuing studies toward the PhD.
Credits and Courses
Minimum degree requirement is 54 credits beyond the bachelor’s degree, at least 27 of which must be earned in residence at UWM.
| Code | Title | Credits |
|---|---|---|
| Select at least 27 credits in formal coursework and seminars | 27 | |
| Select 4 colloquium credits | 4 | |
| Select 23 credits in independent reading and/or study, or research | 23 | |
| Total Credits | 54 | |
At least 30 of the 54 credits must be in biological sciences; 12 credits may be earned in allied sciences, including those in the secondary area of concentration or minor field(s).
Teaching and Research Assistantships are the primary form of financial support for Biological Sciences graduate students. These positions provide a salary and tuition remission. Some small scholarships are also available. Click below for more details.